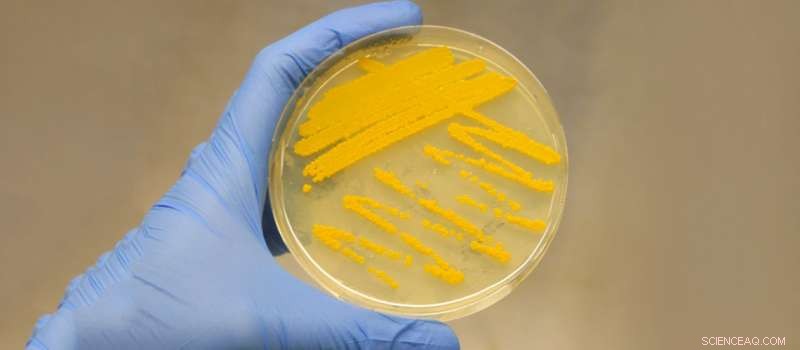
Unlocking Hidden Antibiotics: How CRISPR‑Cas9 Activates Silent Gene Clusters

Small perturbation, large impact: Antibiotic, auroramycin, was awakened through the CRISPR-Cas9 promoter knock-in strategy. Credit: A*STAR Institute of Chemical and Engineering Sciences
The bacterium Streptomyces roseosporus is the source of many common antibiotics such as daptomycin, which is active against methicillin-resistant Staphylococcus aureus (MRSA) and glycopeptide-resistant enterococci. A*STAR researchers have just unearthed a new antibiotic, auroramycin, from a silent biosynthetic gene cluster discovered in the S. roseosporus genome, and believe there are many more just waiting to be found.
"This strain of bacteria is very well studied. It's interesting that, even after so many molecules have been discovered, we now have a new antibiotic simply because we have the tools to access it," explains Yee Hwee Lim of the A*STAR Institute of Chemical and Engineering Sciences and Fong Tian Wong of the A*STAR Molecular Engineering Lab. Lim, Wong and colleagues used CRISPR-Cas9 to introduce a potent gene transcription activator—the kasO* promoter—into the bacterial genome to activate expression of an entire cryptic biosynthetic gene cluster. The gene cluster was found to encode auroramycin, an antibiotic with potent antibacterial activity against Gram-positive bacteria, including MRSA and vancomycin-resistant Enterococcus faecalis (VRE).
"Initially, we didn't know what kind of molecule we were getting. It took a while for us to figure out what we were working with," describes Lim and Wong. The cluster was predicted to encode a type I polyketide synthase but, due to the high guanine-cytosine content and repetitive sequences within the genes, assembly of the genome was actually incomplete. "We did have some clues—we expected it probably had a sugar and a polyene, but we didn't know how big it was."
Throughout their project, the researchers were able to rectify the sequence, whilst isolating and characterizing the compound itself. "Considering it was silenced under normal circumstances, the yield was actually quite high," remarks Lim. "This is really without much optimization at all—we just put in the transcription activator and cultured the bacteria, and then we get all this compound."
Despite uncharacteristically high yields, the compound's light- and acid- sensitive properties complicated the downstream analysis. "At first we'd have the compound basically decompose in front of us. We'd be working with it, thought we had it, but then when we tried to do an analysis to see what we've got, we'd see we'd lost it. Our purification process had to be thoroughly optimized."
Auroramycin joins a growing collection of natural molecules with bioactive properties found to be synthesized by the actinomycete order of bacteria. Lim and her colleagues are in the process of preparing another paper which further describes the molecule's bioactivity and mode of action.